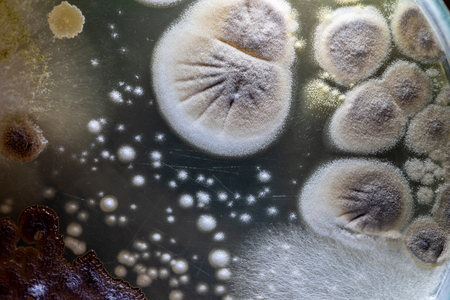

写真素材 - Colony characteristic of Actinomyces, Bacteria, yeast and Mold on selective media from soil samples for study in laboratory microbiology.
作品情報
Colony characteristic of Actinomyces, Bacteria, yeast and Mold on selective media from soil samples for study in laboratory microbiology.
- ID:120031687
- 作品種別:写真
- 作者名:sinhyu
キーワード
- abstract
- actinomyces
- agar
- analysis
- background
- bacteria
- bacterial
- bacterium
- biology
- biotechnology
- characteristic
- colonies
- colony
- culture
- danger
- dirty
- disease
- dish
- education
- equipment
- experiment
- germs
- growing
- growth
- healthcare
- hygiene
- identification
- isolated
- lab
- laboratory
- media
- medical
- medium
- micro
- microbial
- microbiology
- mold
- organism
- pattern
- petri
- plate
- research
- sample
- science
- soil samples
- species
- test
- texture
- white
- yeast
類似作品
Colonies of dif...
Mold Beautiful,...
Microbiology
Bacteria and vi...
Macro view of a...
Backgrounds of ...
Bacteria of dif...
Realistic molec...
Anthrax.
Mold Beautiful,...
Bacterial patho...
Bacteria macro ...
microbial cultu...
Microscopic fun...
Rusty old steel...
Petri dish with...
mysterious abst...
Mold Beautiful,...
Colonies of dif...
Egg parasite in...
Streptococcus p...
Backgrounds of ...
Examining Bacte...
Backgrounds of ...
Multiple bacter...
Backgrounds of ...
Microbial growt...
Closeup for pla...
The beautiful j...
Texture liquid ...
The mosquito la...
Study Movement ...
Red blood cells...
Dirt on the car...
Macro shot of t...
Doctor's hand h...
amazing salt cr...
The human whipw...
3D microscope c...
White blood cel...
Bacterial colon...
Rhizopus (bread...
tablet in water...
bacteria colony...
Paramecium is a...
Bilophila wadsw...
close up of 3d ...
A vibrant, clos...
bacteria colony...